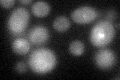
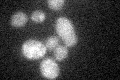
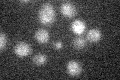

View description
Glycerol kinase, converts glycerol to glycerol-3-phosphate; glucose repression of expression is mediated by Adr1p and Ino2p-Ino4p; derepression of expression on non-fermentable carbon sources is mediated by Opi1p and Rsf1p
Localization:
Intensity:
Fold change:
Significance:
-
C’ GFP library in SD

below threshold15.25 -
N' NOP1pr-GFP in SD

mitochondria92.2306 -
N' TEF2pr-mCherry in SD

mitochondria92.321 -
N' NATIVEpr-GFP in SD

mitochondria17.8975 -
N' TEF2pr-VC and Cyto-VN in SD

#N/A0 -
C’ GFP library in SD+DTT
cytosol16.381.07No -
C’ GFP library in SD+H2O2
cytosol16.231.06No -
C’ GFP library in Starvation Media
cytosol16.761.09No -
C’ GFP library on the background of Pup2-DaMP

below threshold -
C’ GFP library on the background of CCT mutant

below threshold17.83941.169No
